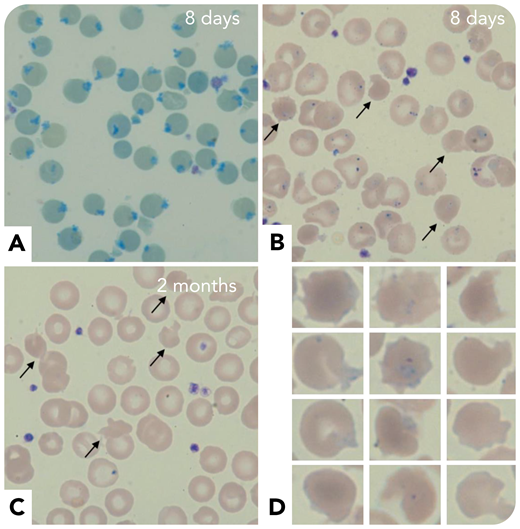
A newborn presented at 8 days of life with neonatal jaundice, hemoglobin of 10.9 g/dL, and mean corpuscular volume of 102 fL. An abnormal reticulocyte scattergram led to the preparation of a blood smear after cresyl blue staining. All erythrocytes exhibited peripheric blue inclusions corresponding to Heinz bodies (panel A; ×50 objective; original magnification ×500) with reticulocyte count of 87 × 109/L. May-Grünwald-Giemsa staining showed anisopoïkilocytosis, intraerythrocytic inclusions including Pappenheimer bodies, and 5% to 10% hyperdense cells (panel B, arrows; ×50 objective; original magnification ×500). Three days later, hemoglobin decreased to 6.3 g/dL, with a reticulocyte count of 176 × 109/L. The result of a direct antiglobulin test was negative. Extensive enzyme assays, ektacytometry, hemoglobin electrophoresis, and molecular analysis of α and β-genes were normal. Three erythrocyte transfusions were needed before clinicobiological improvement. At 2 months, Heinz bodies were no longer visible, but 2% to 3% hyperdense and irregular erythrocytes (pyknocytes) could still be seen (panels C-D; ×50 objective; original magnification ×500). The diagnosis of infantile pyknocytosis was finally retained retrospectively, after hemoglobin improvement and disappearance of pyknocytes.

A newborn presented at 8 days of life with neonatal jaundice, hemoglobin of 10.9 g/dL, and mean corpuscular volume of 102 fL. An abnormal reticulocyte scattergram led to the preparation of a blood smear after cresyl blue staining. All erythrocytes exhibited peripheric blue inclusions corresponding to Heinz bodies (panel A; ×50 objective; original magnification ×500) with reticulocyte count of 87 × 109/L. May-Grünwald-Giemsa staining showed anisopoïkilocytosis, intraerythrocytic inclusions including Pappenheimer bodies, and 5% to 10% hyperdense cells (panel B, arrows; ×50 objective; original magnification ×500). Three days later, hemoglobin decreased to 6.3 g/dL, with a reticulocyte count of 176 × 109/L. The result of a direct antiglobulin test was negative. Extensive enzyme assays, ektacytometry, hemoglobin electrophoresis, and molecular analysis of α and β-genes were normal. Three erythrocyte transfusions were needed before clinicobiological improvement. At 2 months, Heinz bodies were no longer visible, but 2% to 3% hyperdense and irregular erythrocytes (pyknocytes) could still be seen (panels C-D; ×50 objective; original magnification ×500). The diagnosis of infantile pyknocytosis was finally retained retrospectively, after hemoglobin improvement and disappearance of pyknocytes.
Infantile pyknocytosis is a rare cause of neonatal jaundice associated with transient hemolytic anemia, with a favorable outcome after 4 to 6 months. Diagnosis is based on cytology that usually shows numerous pyknocytes and exclusion of other causes. Pathophysiology is unclear and probably involves oxidative stress, as illustrated by this case with numerous Heinz bodies.
A newborn presented at 8 days of life with neonatal jaundice, hemoglobin of 10.9 g/dL, and mean corpuscular volume of 102 fL. An abnormal reticulocyte scattergram led to the preparation of a blood smear after cresyl blue staining. All erythrocytes exhibited peripheric blue inclusions corresponding to Heinz bodies (panel A; ×50 objective; original magnification ×500) with reticulocyte count of 87 × 109/L. May-Grünwald-Giemsa staining showed anisopoïkilocytosis, intraerythrocytic inclusions including Pappenheimer bodies, and 5% to 10% hyperdense cells (panel B, arrows; ×50 objective; original magnification ×500). Three days later, hemoglobin decreased to 6.3 g/dL, with a reticulocyte count of 176 × 109/L. The result of a direct antiglobulin test was negative. Extensive enzyme assays, ektacytometry, hemoglobin electrophoresis, and molecular analysis of α and β-genes were normal. Three erythrocyte transfusions were needed before clinicobiological improvement. At 2 months, Heinz bodies were no longer visible, but 2% to 3% hyperdense and irregular erythrocytes (pyknocytes) could still be seen (panels C-D; ×50 objective; original magnification ×500). The diagnosis of infantile pyknocytosis was finally retained retrospectively, after hemoglobin improvement and disappearance of pyknocytes.
Infantile pyknocytosis is a rare cause of neonatal jaundice associated with transient hemolytic anemia, with a favorable outcome after 4 to 6 months. Diagnosis is based on cytology that usually shows numerous pyknocytes and exclusion of other causes. Pathophysiology is unclear and probably involves oxidative stress, as illustrated by this case with numerous Heinz bodies.
For additional images, visit the ASH Image Bank, a reference and teaching tool that is continually updated with new atlas and case study images. For more information, visit http://imagebank.hematology.org.